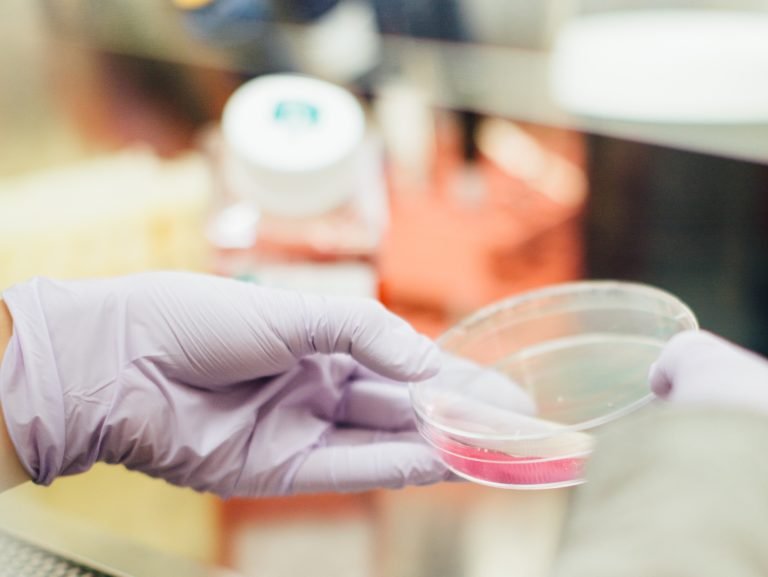

From the study of diseases to developing less invasive surgical techniques, medical researchers rely on whole body donation to push medicine forward. The resulting advances lead to improved medical care and lowered surgical costs. Here are some examples of how whole-body donation has helped advance medical science:
- Anatomy labs for medical universities
- The development of implanted medical devices such as pacemakers and defibrillators
- The development of surgical robotic equipment
- Training physicians and surgeons on new, more effective surgical and medical procedures
- Developing better medication delivery systems
- Research of specific diseases such as cancer, Alzheimer’s, cardiovascular disease, etc.
Unfortunately, MedCure is not able to guarantee that a donor will be placed with a specific research program or educational institution. We work with a large network of medical researchers and educators, each of which has varying needs at different points in time. Because of this, and our goal to try to ensure that every donor’s gift be utilized in a timely manner, placement relies heavily on what our medical community needs at the time of a donor’s passing. However, we do take a donor’s medical history into consideration when determining placement.
Request a Family Letter
At MedCure, we realize that the ever-changing needs of the medical community can frustrate the best intentions of those who want their whole-body donation to have the greatest level of impact on the conditions that have touched their lives. However, we also understand the selfless impulses behind the desire to create a healthier future for others. Even if we are unable to place a donor’s gift with their preferred research program, we want their families to know how their loved one’s gift helped to benefit medical science. For this reason, we also offer the option for our donor families to receive a letter after the donation process has been completed, which will outline the areas of research in which their loved one has been able to participate.



